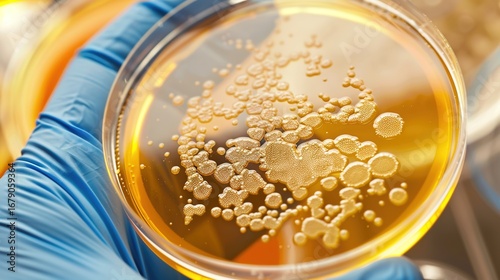

Download sample
File Details
Published: 2025-09-01 14:28:42.725087 Category: Graphic Resources Type: Illustration Model release: NoShare
Close-Up Petri Dish with Microbe Colony: Detailed View of Bacterial/Fungal Growth, Textured Colonies, and Nutrient Agar Surface in Laboratory Setting
Contributor: bo tang
ID : 1679059364
